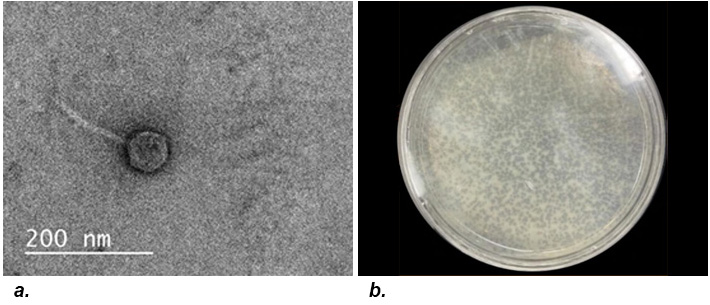
TEM images of two phages

CUREs students tackle real-world problems while building the professional skills needed to launch impactful careers.

Figure 1. Structure of BHE's Course-Based Undergraduate Research Experience Program
The Department of Biology, Health, and the Environment (BHE)'s Course Based Undergraduate Research Experiences (CUREs) program provides students with structured opportunities to engage in original research targeting some of the most pressing biological challenges of our time as part of their degree progression. Beginning in their first year, students gain progressively deeper exposure to the research process through projects spanning topics from biodiversity conservation to cancer prevention. All CURE themes are grounded in the department’s One Health framework—an integrative perspective recognizing the interconnectedness of human, animal, and environmental health.
Program Contacts
Dr. Mariah Hopkins, Director of BHE CURE Labs — Mariah.Hopkins@utsa.edu
Donna Degen, CURE Lab Coordinator — Donna.Degen@utsa.edu
Freshman Opportunities
Biosciences II Mini-CURE
All students who take BIO 1221 Biosciences II lab are introduced to original research through a mini-CURE in which students work together to survey biodiversity in the San Antonio Area. These efforts assist with monitoring threatened species, tracking invasive species, developing land management practices, and informing conservation decisions.
Biosciences II Faculty Coordinator: James Rogers
One Health Areas Targeted: Animal Health, Environmental Health
Biology Research Initiative
A year-long course open to Sophomores and above
In their Sophomore year, BHE students can elect to either take a traditional laboratory pathway or participate in the year-long Biology Research Initiative (BRI), comprised of BIO 2073 or ES 2003 (Fall) and BIO 3053 or ES 3003 (Spring). The BRI forms the heart of the BHE CUREs program, offering students the opportunity to conduct extended research in collaboration with external partners on topics ranging from combatting the rise of antibiotic- resistant bacteria to investigating the genetic basis for tumor formation in cancer. As a result, BHE students are helping to solve real-world problems, while gaining valuable competencies, all as part of their degree program.
The BRI is open to Sophomores, Juniors, and Seniors who have taken Biosciences I & II with labs (for BIO 2073/3053) or Environmental Zoology & Environmental Botany with labs (for ES 2003/3003). Students register for the BRI as they would a typical course during their Fall enrollment window on a first-come first-served basis. Students must register for both the lecture and lab sections (e.g. AA and A1) and must commit to the full year-long course sequence. The BRI course sequence satisfies the Advanced Laboratory Requirement for the BS Biology and BS Health Sciences and can contribute towards the Area of Study courses for the BS Environmental Science. All BRI students will present their research at a Research Symposium at the end of the Spring semester.
2026–2027 Biology Research Initiative Offerings
Bacteriophage Discovery & Genomics
- Section A1/AA: MW 10–11:50
- Section F1/FA: MW 1–2:50
Figure 2. a. A TEM image of the phage CarisSwetlik; b. Plaque morphology/Webb Plate of phage KNG13. Both phages were discovered and named by BHE students
The Howard Hughes Medical Institute (HHMI)'s SEA Phages program is a two-semester sequence in which students isolate and characterize novel bacteriophages from soil samples. Bacteriophages are viruses that infect and kill bacteria but have no impact upon eukaryotic cells. They have a number of uses to humans ranging from serving as an environmental safety metric to serving as a biotechnological tool to combat antibiotic resistant bacteria. However, while there are approximately 1031 phage particles in the biosphere, only ~3000 have been characterized genomically. BHE students have the opportunity to assist in an international effort coordinated by HHMI to find and characterize new bacteriophages. In the first semester ("Phage Discovery"), students will collect soil samples and isolate novel phages. In the second semester ("Phage Genomics"), students will analyze a novel phage's genome using comparative and bioinformatic methods, adding new genomes to a global scientific database. To date, BHE students have discovered and named >40 new bacteriophages!
Instructor(s): Amy Eich-Johnson and Nick Young
One Health Areas Targeted: Human Health, Environmental Health
Microbial Diversity & Antibiotic Discovery (MDAD)
- Section B1/BA: T 1–3:50, F 12–2
- Section E1/EA: T 9–11:50, F 9–11

Figure 3. a. Zones of inhibition reveal antimicrobial compounds isolated from soil bacteria by BHE students; b. MDAD students collecting soil samples
Students enrolled in this CURE will explore the diversity of microbes across different habitats and find new sources of antibiotics as part of the Tiny Earth international network of scientists (Tiny Earth—Studentsourcing Antibiotic Discovery). According to the World Health Organization, antibiotic resistant bacteria are one of the greatest threats to human health and food security today. In the U.S. alone, there are more than 2.8 million antibiotic-resistant infections each year, responsible for 35,000 deaths. Soil microbes have been a prominent source of antibiotics since the discovery of penicillin in 1928. In this CURE, students will help address the emerging global health threat of antibiotic resistance by isolating bacteria directly from UT San Antonio campus soils, characterizing differences in these soil microbial communities and investigating their inhibitory properties. Students gain hands-on experience with microbiological techniques and even perform chemical extractions on their active soil bacteria to elucidate the compounds responsible for the antimicrobial activity. Several bioactive compounds produced by campus soil bacteria have been identified by MDAD students to-date.
Instructor(s): Donna Degen
One Health Areas Targeted: Human Health, Environmental Health
Genomic Approaches to Health
- Section C1/CA: MW 1–2:50

Figure 4. a. Student generated genomic neighborhood map; b. Many tumor suppressor genes and oncogenes are shared between humans and fruit flies
Students in this section explore how genomics and bioinformatics can be used in health research through participation in two national CUREs programs—the Genomics Education Partnership (Fall) & FlyCURE (Spring). In this project we will be using network analysis approaches to better understand the evolution and function of biological pathways. The Pathways Project focuses on annotating genes found in well characterized signaling and metabolic pathways across the Drosophila genus. The current focus is on the insulin signaling pathway which is well conserved across eukaryotes and critical to growth and metabolic homeostasis. The long-term goal of the Pathways Project is to analyze how the regulatory regions of genes evolve in the context of their positions within a network and we anticipate that other pathways will eventually be part of the analysis. In Spring, students participate in the NSF-funded Fly-CURE, which centers on characterizing and mapping novel EMS-induced mutations isolated in a genetic screen for genes that regulate cell growth and cell division within the developing Drosophila eye. The scientific data generated by our students will contribute to a better understanding of the genetic intricacies regulating developmental processes across species, including humans. Opportunities to co-author publications through the GEP and FlyCURE may be available to motivated students.
Instructor(s): Amy Eich-Johnson
One Health Areas Targeted: Human Health, Animal Health
Wildlife Biogeography & Environmental Health
- Section D1/DA: R 1-3:50; F 9–10:50

Figure 5. a. Gray Fox (Urocyon cinereoargenteus) captured via remote camera trap by BHE students; b. Students conduct laboratory analyses screening local waterways for endangered species and wildlife pathogens using environmental DNA
This course immerses students in the science of wildlife and disease ecology using cutting edge remote detection tools and artificial intelligence. Through an integrated blend of camera trapping and environmental DNA (eDNA) analysis, students learn how to monitor species across landscapes and to make environmental health assessments. In Fall, students participate in Snapshot USA, a nationwide mammal monitoring project led by scientists at the Smithsonian Institution and the North Carolina Museum of Natural Sciences. In the Spring, students survey the health of local waterways, using eDNA to determine the presence of endangered species and the distribution of specific wildlife pathogens of great importance such as chytrid fungus and ranavirus. By the end of the course, students will be able to evaluate wildlife presence, model species distributions, and characterize pathogen patterns that shape ecosystem and public health.
Instructor(s): Dr. Mariah Hopkins
One Health Areas Targeted: Animal Health, Environmental Health
Research Methods in Zoo Biology: Behavioral and Bioacoustic Approaches to the Conservation of Threatened Species
- Section G1/GA: T 1–3:50; F 12–1:50

Figure 6. a. BHE student study subject Western Lowland Gorilla (Gorilla gorilla gorilla) at the San Antonio Zoo; b. Oscillogram (top) and Spectogram (bottom) of a roar shriek vocalization from a critically endangered Black and White Ruffed Lemur (Varecia variegata) visualized in Kaleidoscope Pro (Wildlife Acoustics)
Zoos provide access to species that are rarely seen—and often difficult to study—in their natural habitats, offering valuable opportunities to investigate the basic biology of threatened species. In this course, students use behavioral observations and bioacoustic analyses to examine how zoo animals communicate, interact, and respond to their environment by exploring vocal behavior, social dynamics, activity patterns, and behavioral indicators of health and welfare. Through structured fieldwork, students collect and interpret data that reveal fundamental aspects of animal behavior, cognition, and physiology, with particular attention to threatened species whose natural history can be meaningfully explored in managed settings. This course equips students with practical research experience while demonstrating how behavioral and acoustic tools deepen our understanding of animal biology and inform approaches to welfare and conservation. Students must provide their own transportation to the San Antonio Zoo.
Instructor(s): Dr. Mariah Hopkins
One Health Areas Targeted: Animal Health
FAQs
What is the benefit of joining the BRI?
The goal of the BRI is to promote career readiness by providing students with hands-on experience in modern scientific techniques used across the biological sciences. The program serves as an excellent entry point into biological research and helps students stand out in job applications and professional school admissions cycles.
Throughout the year, you will work closely with the same faculty mentor and a consistent cohort of peers, allowing you to build a strong scientific community. This sustained mentorship also gives you the opportunity to develop meaningful relationships with faculty who may become valuable references or letter writers for your future academic and professional pursuits.
What type of commitment is needed to join the BRI?
Students must commit to a full year of classes—BIO 2073/ES 2003 (3 cr) in the Fall and BIO 3053/ES 3003 (3 cr) in the Spring.
Do I need to apply to join the BRI?
No. Students register for the BRI the same way they would register for any other class. Enrollment in the BRI is first-come first-served. During your enrollment window, identify the section of BIO 2073/ES 2003 that interests you and enroll. Students must enroll in both lecture and lab sections (e.g. A1/AA, B1/BA). For example, if I am interested in enrolling in Research Methods in Zoo Biology, I would enroll in either BIO 2073 G1 & BIO 2073 GA or ES 2003 GA & ES 2003 GA.
Does the BRI meet any of my degree requirements?
Yes! The BRI satisfies the Advanced Laboratory Requirement for the BS Biology and BS Health Sciences. It also contributes towards the Area of Study requirement for ES majors. This is a unique opportunity for you to gain valuable research experience and contribute towards solving a real world problem—all while completing requirements for your degree!
The section I want is full. What should I do?
We recommend that all students who are interested get on the waitlist. There is typically some movement in these classes the closer we get to the Fall. The size of the waitlist also lets us know if there is student demand for an additional section.
Additional Upper-Division Opportunities
BIO 3382: Sophomore Research Initiative Peer Mentor
Successful students can return as a peer mentor for the Biology Research Initiative in a laboratory in which they were previously enrolled and which they completed with a grade of "A" or "B." Students attend group meetings associated with the lab, help with set up of the laboratories, and help to guide peers through the research process. Peer mentors must commit to one year (two consecutive semesters of BIO 3382).
Instructor(s): Donna Degen, Dr. Mariah Hopkins, Amy Jones, Nick Young
One Health Areas Targeted: Human Health, Animal Health, Environmental Health
BIO 4923/ES 4993: Laboratory Research
Select students may build on the research they began as part of the Biology Research Initiative, working closely with their BRI instructor. Permission must be obtained in writing from the faculty mentor, the student's advisor, the Department Chair, and the Dean of the College.
Instructor(s): Donna Degen, Dr. Mariah Hopkins, Amy Jones, Nick Young
One Health Areas Targeted: Human Health, Animal Health, Environmental Health
BIO 4973/ES 4973 Grant Writing and Research Design for Competitive Fellowships
This course guides students through the process of developing a competitive research proposal suitable for submission to external funding organizations such as the NSF Graduate Research Fellowship Program (GRFP), Fulbright, or comparable agencies. Students learn the principles of research design, proposal structure, and effective scientific communication while refining their ability to articulate research questions, justify methodological approaches, and situate their work within broader scholarly and societal contexts.
Topics change yearly. AY 2026/2027 offerings include:
Global Issues in Conservation (Cross-Listed with HON 3313)
This course introduces students to international research pathways by exploring global conservation topics, identifying faculty mentors, and developing strategies for building professional research connections. Students learn to locate opportunities in San Antonio and beyond that can serve as entry points into longer-term international research experiences. Emphasis is placed on transferable skills—including writing for diverse audiences, navigating cross cultural communication, interpreting peer reviewed research, and linking their academic major to contemporary environmental issues.
Instructor: Alexandra Shelton
One Health Areas Targeted: Animal Health, Environmental Health
BIO 4953/ES 4953 Special Studies in Biology/ Environmental Science
Topics change yearly. Fall 2026 opportunities include:
Special Topics: Tropical Fish Ecophysiology CURE
Students will perform a laboratory experiment to characterize the thermal tolerance and acclimation capacity of three freshwater fishes of tropical origin to forecast invasion potential under warming caused by climate change and urbanization. This research will culminate in student-led presentation of research findings at the Annual Meeting of the Texas Chapter of the American Fisheries Society in early 2027. Students will gain skills in experimental design, animal husbandry, data analysis, and dissemination of science. The course will also include lectures and paper discussions on topics including global change biology, conservation biology, and ecophysiology. Some outside-of-class commitments are required (e.g., weekly care for fish).
Instructor(s): Dr. Matthew Troia
One Health Areas Targeted: Animal Health, Environmental Health


